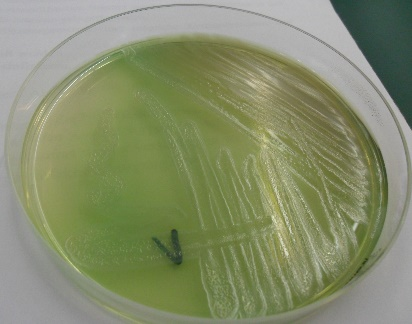
ͼƬ3.png

|
自2025年10月1日起,随着新版《中国药典》的实施,铜绿假单胞菌正式取代了大肠杆菌的地位,成为了无菌检查方法适用性试验中的革兰氏阴性菌主力军。
一、铜绿假单胞菌的“危险”简历
选择铜绿假单胞菌作为新标杆,源于它一系列令人警惕的生物学特性。
无处不在的条件致病菌:铜绿假单胞菌在自然界中分布极广,在水、土壤、空气甚至医院环境中都能存活,一旦侵入免疫力低下者的体内或通过非无菌产品(如眼用制剂、伤口护理产品)接触人体,可能引发严重的呼吸道感染、血流感染甚至败血症。

强大的环境生存与耐药能力:该菌对环境的适应力极强,具有显著的热耐受性、pH耐受性和氧化应激耐受性,这意味着它能存在于一些相对严苛的制药环境中。更棘手的是,铜绿假单胞菌以其强大的生物膜形成能力和复杂的抗生素耐药机制而臭名昭著。
完美的检测对象:从无菌检测方法学的角度看,铜绿假单胞菌的这些特性使得它比大肠埃希菌更能模拟实际生产中可能遇到的、最难检出的污染风险。
二、检测技术:从传统培养到分子快检
对铜绿假单胞菌的有效监控,离不开可靠的检测技术。目前,检测方法主要分为两大类:
1. 传统方法(金标准与基础)
培养鉴定法:这是药典规定的经典方法。富集微生物,然后培养。通过观察典型的菌落形态、气味,并结合氧化酶试验等生化反应进行鉴定。
适用性验证:在新版药典下,任何无菌检查方法在应用于产品前,都必须使用包括铜绿假单胞菌在内的标准菌株进行“方法适用性试验”,以证明该方法能有效检出该产品中可能存在的微生物。
2. 新兴快速方法
传统培养法虽可靠,但耗时漫长(通常需数天至一周),难以满足细胞治疗产品等短效期产品的快速放行需求。因此,药典已明确允许并规范了快速微生物检测方法(RMM)的应用。
分子生物学检测(如qPCR):这类技术能在数小时内特异性检测出铜绿假单胞菌的DNA,灵敏度极高。国内翼和生物等公司已有成熟的多重PCR无菌检测试剂盒,可一次检测包括铜绿假单胞菌、金黄色葡萄球菌、生孢梭菌、白色念珠菌在内的多种药典关键菌。相对单重的试剂盒而言,多重PCR的设计能够更好地节约检测的时间和成本。
结语
翼和生物细菌真菌检测试剂盒基于自主知识产权的多重PCR技术,可同时检测包括金黄色葡萄球菌、铜绿假单胞菌、枯草芽孢杆菌、生孢梭菌 、白色念珠菌、黑曲霉等6种药典规定菌种。通过优化的引物设计和荧光标记探针,试剂盒的检测限低至10¹ CFU/mL,扩增效率高达88.51%-99.68%,相关性系数(R²)均优于0.99,确保检测结果的可靠性和重复性。
Archiver|手机版|科学网 ( 京ICP备07017567号-12 )
GMT+8, 2026-2-5 06:58
Powered by ScienceNet.cn
Copyright © 2007- 中国科学报社